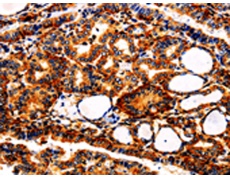
一抗

中文名稱:兔抗APLP1多克隆抗體
|
Background: |
This gene encodes a member of the highly conserved amyloid precursor protein gene family. The encoded protein is a membrane-associated glycoprotein that is cleaved by secretases in a manner similar to amyloid beta A4 precursor protein cleavage. This cleavage liberates an intracellular cytoplasmic fragment that may act as a transcriptional activator. The encoded protein may also play a role in synaptic maturation during cortical development. Alternatively spliced transcript variants encoding different isoforms have been described. |
|
Applications: |
ELISA, WB, IHC |
|
Name of antibody: |
APLP1 |
|
Immunogen: |
Fusion protein of human APLP1 |
|
Full name: |
Amyloid beta (A4) precursor-like protein 1 |
|
Synonyms: |
APLP |
|
SwissProt: |
P51693 |
|
ELISA Recommended dilution: |
500-5000 |
|
IHC positive control: |
Human thyroid cancer and human liver cancer |
|
IHC Recommend dilution: |
25-100 |
|
WB Predicted band size: |
72 kDa |
|
WB Positive control: |
Human fetal brain tissue |
|
WB Recommended dilution: |
500-2000 |


 購物車
購物車 幫助
幫助
 021-54845833/15800441009
021-54845833/15800441009